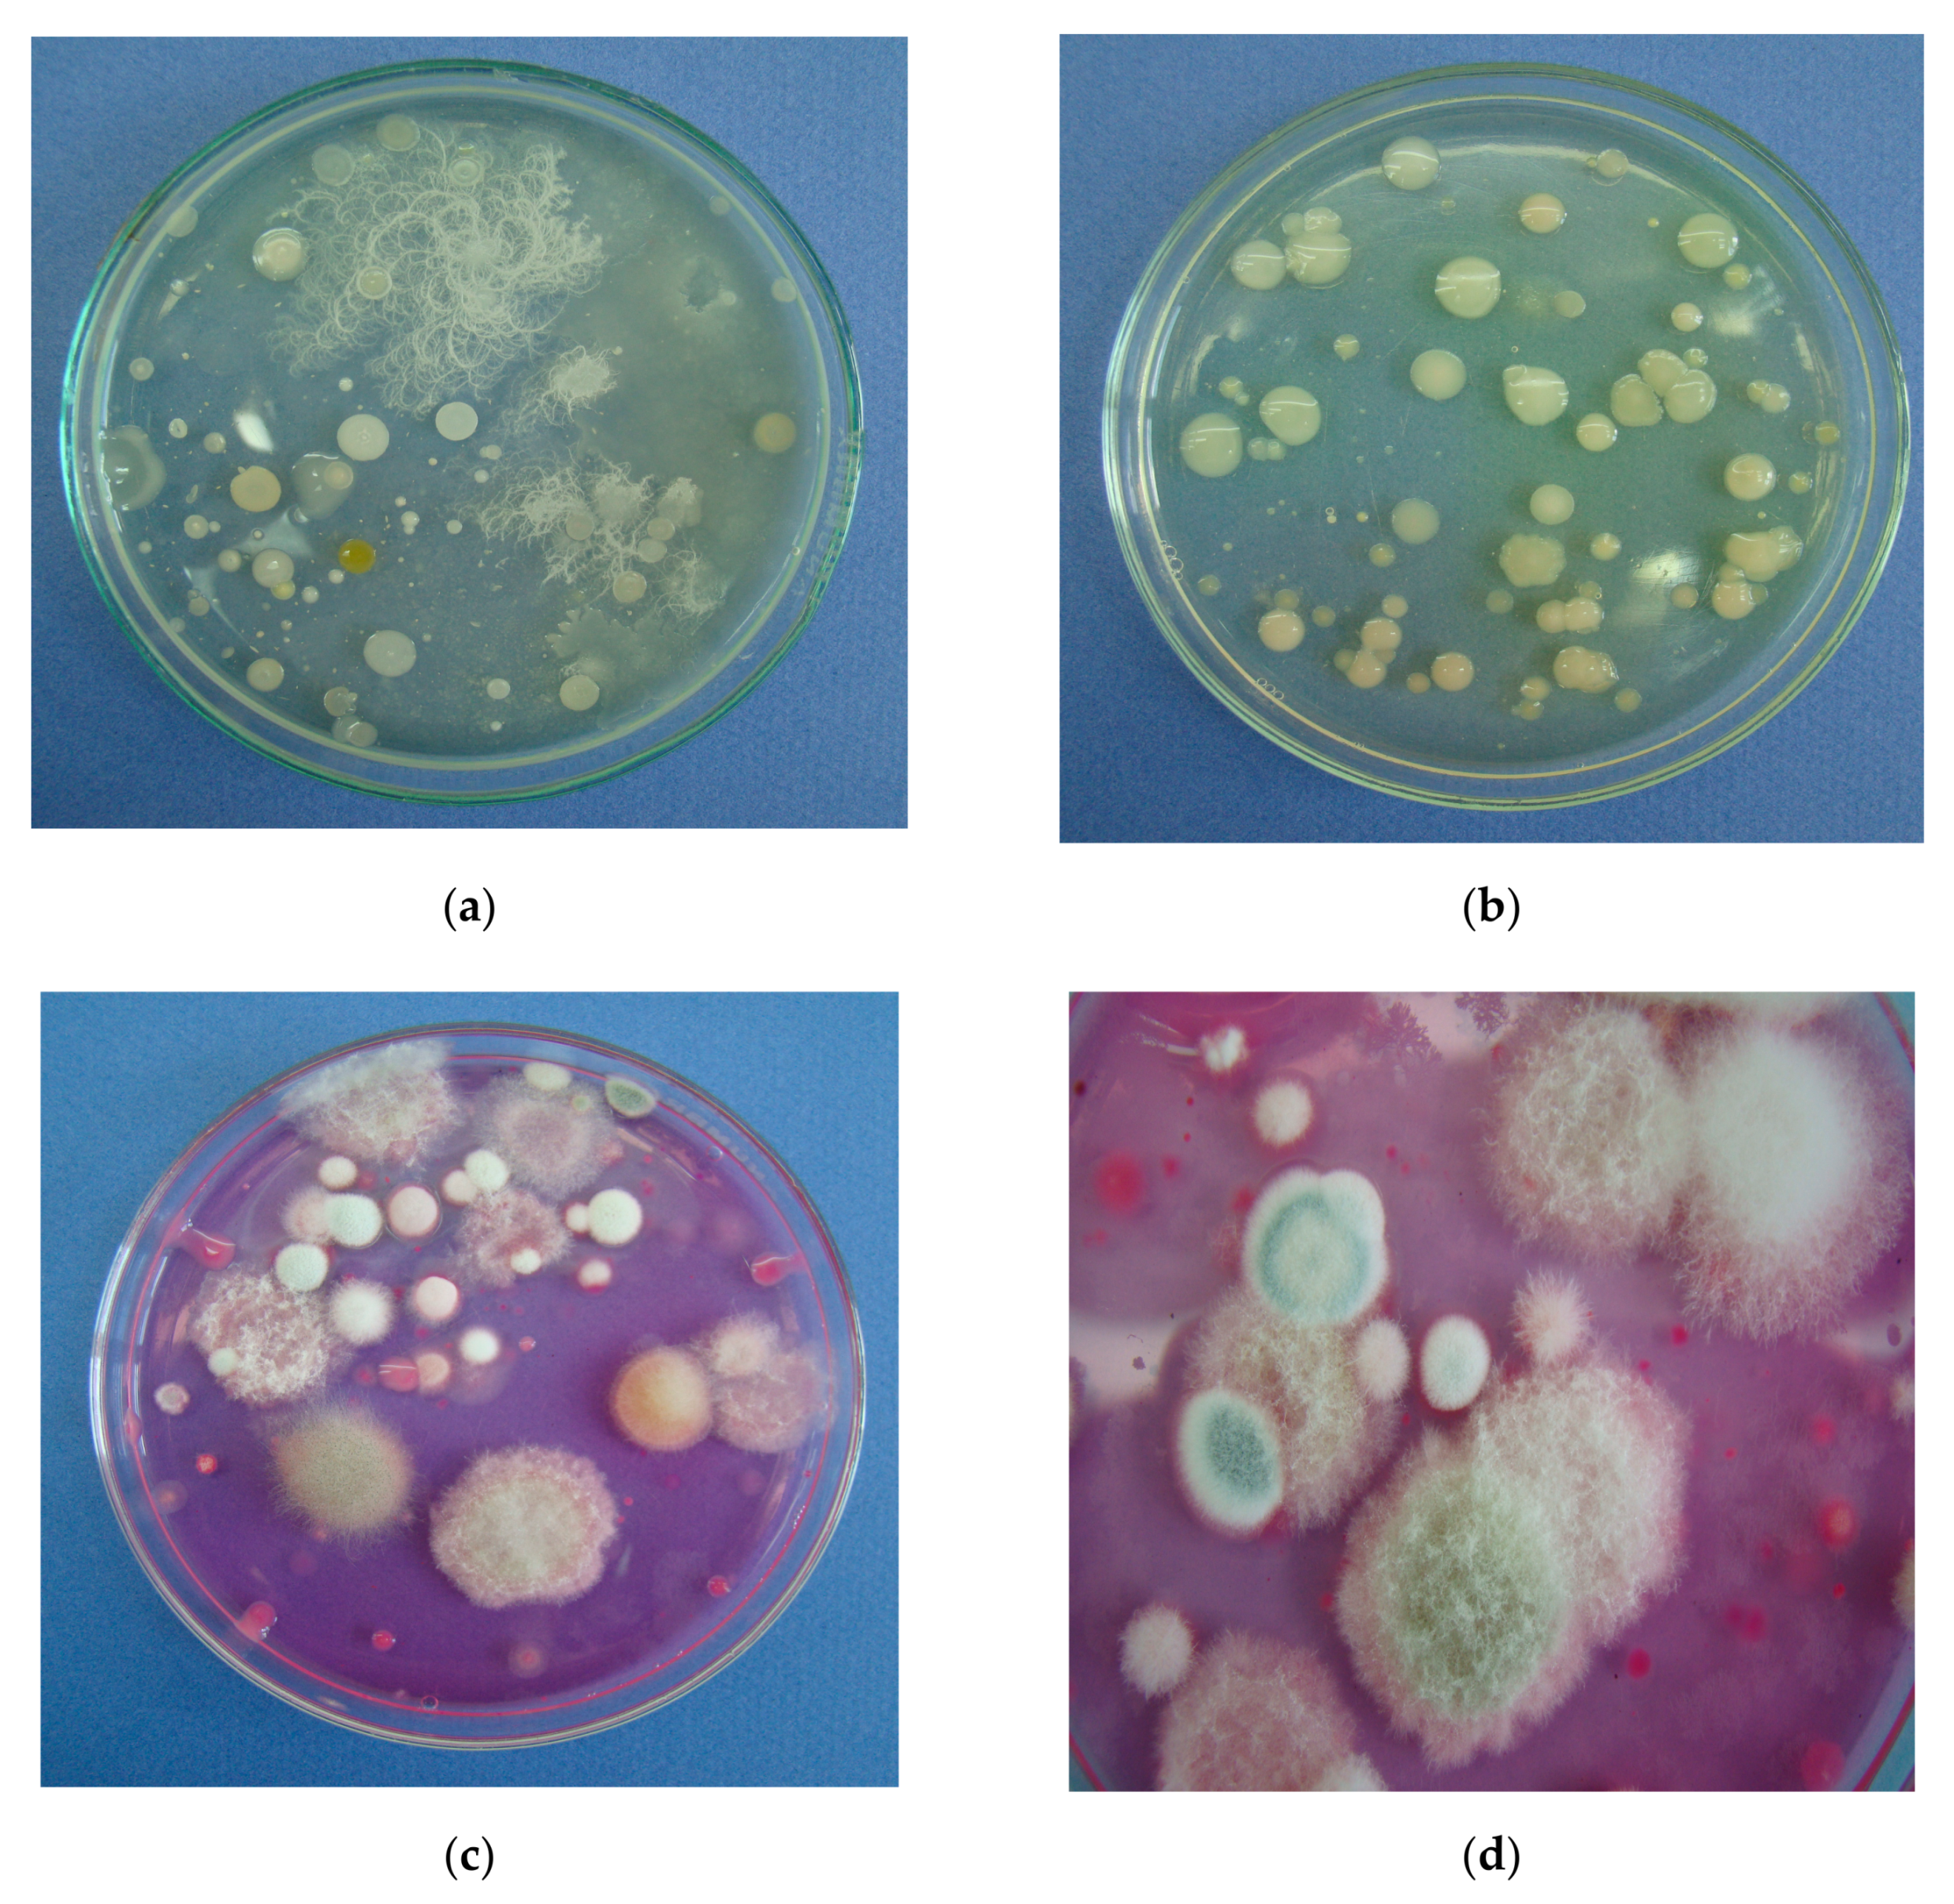
Agronomy 10 01637 g006 Agronomy 10 01637 g006
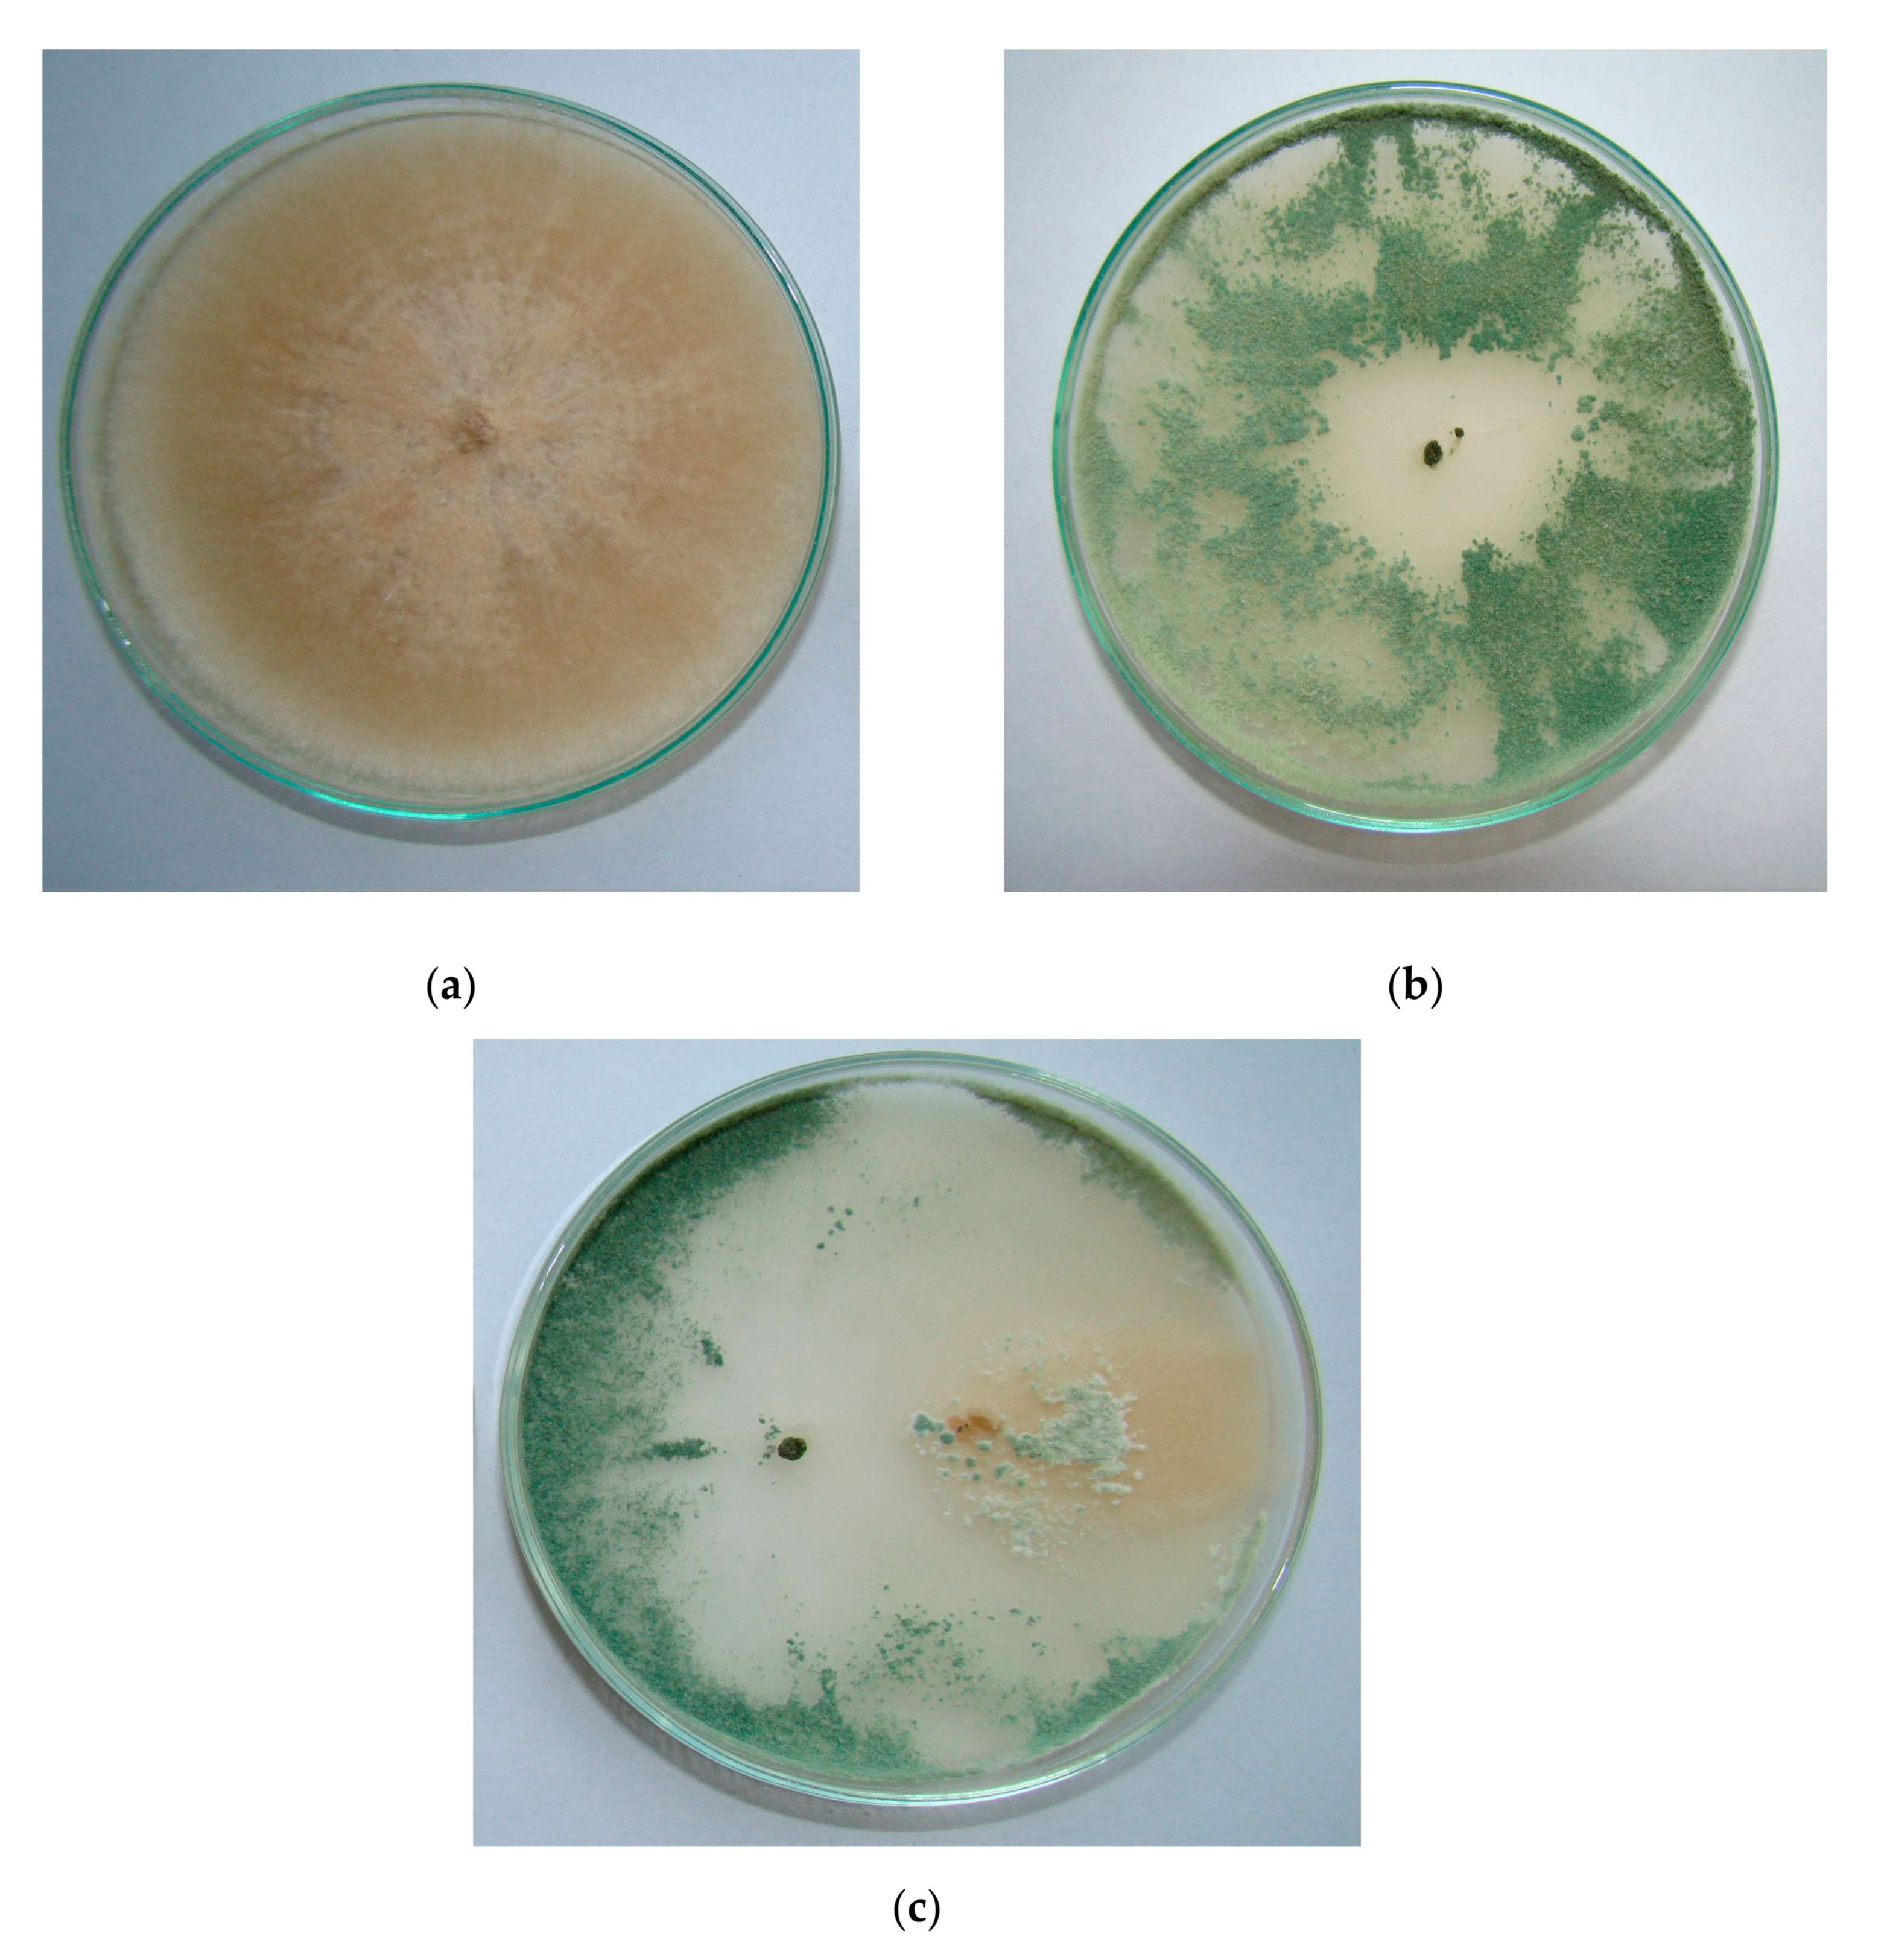
Agronomy 10 01637 g009 Agronomy 10 01637 g009

The Influence of Trichoderma harzianum Rifai T-22 and Other Biostimulants on Rhizosphere Beneficial Microorganisms of Carrot
Abstract
1. Introduction
2. Materials and Methods
2.1. Field Trials
2.2. Laboratory Mycological Analysis
2.3. Laboratory Analysis of Microbial Communities
2.4. Antagonistic Activity of Selected Rhizosphere Fungi of Carrot
2.5. Statistical Analysis
3. Results
4. Discussion
5. Conclusions
Author Contributions
Funding
Acknowledgments
Conflicts of Interest
References
- Szopińska, D.; Jarosz, M.; Sławińska, B. The effect of hydrogen peroxide on seed quality and emergence of carrot (Daucus carota L.). Acta Sci. Pol. Hortorum Cultus 2017, 16, 21–33. [Google Scholar]
- FAOSTAT. Food and Agriculture Organization of the United Nations. Statistics Division 2002. Available online: http://www.fao.org/faostat/en/#data (accessed on 15 September 2020).
- Rachamallu, R.R. Hairy roots production through Agrobacterium rhizogenes genetic transformation from Daucus carota explants. Int. J. Adv. Res. Biol. Sci. 2016, 3, 23–27. Available online: http://s-o-i.org/1.15/ijarbs-2016-3-8-5 (accessed on 15 September 2020).
- Leja, M.; Kamińska, I.; Kramer, M.; Maksylewicz-Kaul, A.; Kammerer, D.; Carle, R.; Baranski, R. The content of phenolic compounds and radical scavenging activity varies with carrot origin and root color. Plant Foods Hum. Nutr. 2013, 68, 163–170. [Google Scholar] [CrossRef]
- Desobry, S.A.; Netto, F.M.; Labuza, T.P. Preservation of β-carotene from carrots. Crit. Rev. Food Sci. Nutr. 1998, 38, 381–396. [Google Scholar] [CrossRef]
- Darvin, M.E.; Sterry, W.; Lademann, J.; Vergou, T. The role of carotenoids in human skin. Molecules 2011, 16, 10491–10506. [Google Scholar] [CrossRef]
- Groot, S.P.C.; van der Wolf, J.M.; Jalink, H.; Langerak, C.J.; van den Bulk, R.W. Challenges for the production of high quality organic seeds. Seed Test. Int. 2004, 127, 12–15. [Google Scholar]
- Sadowski, C.; Lenc, L.; Łukanowski, A. Pytopathological aspect of onion seed production in organic farm. J. Res. Appl. Agric. Eng. 2009, 54, 80–84. [Google Scholar]
- Patkowska, E.; Krawiec, M. Yielding and healthiness of pea cv. ‘Sześciotygodniowy TOR’ after applying biotechnical preparations. Acta Sci. Pol. Hortorum Cultus 2016, 15, 143–156. [Google Scholar]
- Sultana, V.; Baloch, G.N.; Ara, J.; Esteshamul-Haque, S.; Tariq, R.M.; Athar, M. Seaweeds as alternative to chemical pesticides for the management of root diseases of sunflower and tomato. J. Appl. Bot. Food Qual. 2011, 84, 162–168. [Google Scholar]
- Stoleru, V.; Sellitto, V.M. Pest Control in Organic System. In Integrated Pest Management (IPM): Environmentally Sound Pest Management, 1st ed.; Gill, H., Ed.; IntechOpen: London, UK, 2016; pp. 1239–1560. [Google Scholar]
- Koziara, W.; Sulewska, H.; Panasiewicz, K. Effect of resistance stymulator application to some agricultural crops. J. Res. Appl. Agric. Eng. 2006, 51, 82–87. [Google Scholar]
- Patkowska, E. Effect of bio-products on bean yield and bacterial and fungal communities in the rhizosphere and non-rhizosphere. Pol. J. Environ. Stud. 2009, 18, 255–263. [Google Scholar]
- Wadas, W.; Dziugieł, T. Changes in Assimilation Area and Chlorophyll Content of Very Early Potato (Solanum tuberosum L.) Cultivars as Influenced by Biostimulants. Agronomy 2020, 10, 387. [Google Scholar] [CrossRef]
- Reuveni, M.; Sanches, E.; Barbier, M. Curative and Suppressive Activities of Essential Tea Tree Oil against Fungal Plant Pathogens. Agronomy 2020, 10, 609. [Google Scholar] [CrossRef]
- Jamiołkowska, A. Natural Compounds as Elicitors of Plant Resistance Against Diseases and New Biocontrol Strategies. Agronomy 2020, 10, 173. [Google Scholar] [CrossRef]
- Mielniczuk, E.; Skwaryło-Bednarz, B. Fusarium Head Blight, Mycotoxins and Strategies for Their Reduction. Agronomy 2020, 10, 509. [Google Scholar] [CrossRef]
- Raja, N.; Masresha, G. Plant Based Biopesticides: Safer Alternative for Organic Food Production. J. Fertil. Pestic. 2015, 6, 2. [Google Scholar] [CrossRef]
- El-Gremi, S.M.; Draz, I.S.; Youssef, W.A.-E. Biological control of pathogens associated with kernel black point disease of wheat. Crop. Prot. 2017, 91, 13–19. [Google Scholar] [CrossRef]
- Adams, I.P.; Skelton, A.; Macarthur, R.; Hodges, T.; Hinds, H.; Flint, L.; Nath, P.D.; Boonham, N.; Fox, A. Carrot yellow leaf virus is associated with carrot internal necrosis. PLoS ONE 2014, 9, e109125. [Google Scholar] [CrossRef]
- Nesha, R.; Siddiqui, Z.A. Interactions of Pectobacterium carotovorum pv. carotovorum, Xanthomonas campestris pv. carotae, and Meloidogyne javanica on the disease complex of carrot. Int. J. Veget. Sci. 2013, 19, 403–411. [Google Scholar] [CrossRef]
- Lerat, S.; Simao-Beaunoir, A.-M.; Beaulieu, C. Genetic and physiological determinants of Streptomyces scabies pathogenicity. Mol. Plant Pathol. 2009, 10, 579–585. [Google Scholar] [CrossRef]
- Patkowska, E. Soil-borne microorganisms threatening carrot cultivated with the use of cover crops. Acta Sci. Pol. Hortorum Cultus 2020, 19, 71–86. [Google Scholar] [CrossRef]
- Koike, S.T.; Smith, R.F.; Cahn, M.D.; Pryor, B.M. Association of the carrot pathogen Alternaria dauci with new diseases, Alternaria leaf speck, of lettuce and celery in California. Plant Health Prog. 2017, 18, 136–143. [Google Scholar] [CrossRef]
- Zafar, M.M.; Abrar, M.; Umar, M.; Bahoo, M.A.; Khan, N.A.; Salahuddin, M.; Bilal, A.; Abdullah. Screening of different carrot varieties against Alternaria leaf blight and its chemical management. Researcher 2017, 9, 8–14. [Google Scholar] [CrossRef]
- Coles, R.B.; Wicks, T.J. The incidence of Alternaria radicina on carrot seeds, seedlings and roots in South Australia. Austral. Plant Pathol. 2003, 32, 99–104. [Google Scholar] [CrossRef]
- Mazur, S.; Nawrocki, J. The influence of carrot plant control against Alternaria blight on the root health status after storage. Veget. Crops Res. Bull. 2007, 67, 117–125. [Google Scholar] [CrossRef]
- Nawrocki, J.; Mazur, S. Effect of cultivation methods on the health of carrot roots. In Proceedings of the Abstract Book of 3th Congress of PTNO “Science and Gardening Practice for Health and the Environment”, Lublin, Poland, 14–16 September 2011; University of Life Sciences in Lublin: Lublin, Poland, 2011; p. 109. [Google Scholar]
- Park, K.H.; Ryu, K.Y.; Yun, H.J.; Yun, J.C.; Kim, B.S.; Jeong, K.S.; Kwon, Y.S.; Cha, B. Gray mold on carrot caused by Botrytis cinerea in Korea. Res. Plant Dis. 2011, 17, 364–368. [Google Scholar] [CrossRef]
- Aktaruzzaman, M.; Kim, J.Y.; Xu, S.J.; Kim, B.S. First report of postharvest gray mold rot on carrot caused by Botrytis cinerea in Korea. Res. Plant Dis. 2014, 20, 129–131. [Google Scholar] [CrossRef]
- Wagini, N.H.; Abubakar, S. Incidence and severity of common diseases of carrot and their pathogenic agents in northern Nigeria. Katsina J. Natural Appl. Sci. 2015, 4, 212–219. [Google Scholar]
- Koutouan, C.; Clerc, V.L.; Baltenweck, R.; Claudel, P.; Halter, D.; Hugueney, P.; Hamama, L.; Suel, A.; Huet, S.; Merle, M.H.B.; et al. Link between carrot leaf secondary metabolites and resistance to Alternaria dauci. Sci. Rep. 2018, 8, 13746. [Google Scholar] [CrossRef] [PubMed]
- Le Clerc, V.; Aubert, C.; Cottet, V.; Yovanopoulos, C.; Piquet, M.; Suel, A.; Huet, S.; Koutouan, C.; Hamama, L.; Chalot, G.; et al. Breeding for Carrot Resistance to Alternaria dauci without Compromising Taste. Mol. Breed. 2019, 39, 59. [Google Scholar] [CrossRef]
- Lamichhane, J.R.; Durr, C.; Schwanck, A.A.; Robin, M.H.; Sarthou, J.P.; Cellier, V.; Messean, A.; Aubertot, J.N. Integrated management of damping-off diseases. A review. Agron. Sust. Develop. 2017, 37, 25. [Google Scholar] [CrossRef]
- Baturo-Cieśniewska, A.; Łukanowski, A.; Koczwara, K.; Lenc, L. Development of Sclerotinia sclerotiorum (Lib.) de Bary on stored carrot treated with Pythium oligandrum Drechsler determined by qPCR assay. Acta Sci. Pol. Hortorum Cultus 2018, 17, 111–121. [Google Scholar] [CrossRef]
- Siddiqui, Z.A.; Hashmi, A.; Khan, M.R.; Parveen, A. Management of bacteria Pectobacterium carotovorum, Xanthomonas campestris pv. carotae, and fungi Rhizoctonia solani, Fusarium solani and Alternaria dauci with silicon dioxide nanoparticles on carrot. Internat. J. Veget. Sci. 2019. [Google Scholar] [CrossRef]
- Boiteux, L.S.; Reis, A.; Fonseca, M.E.N.; Lourenço, V.; Costa, A.F. Powdery mildew caused by Erysiphe heraclei: A novel field disease of carrot (Daucus carota) in Brazil. Plant Dis. 2017, 101, 1544. [Google Scholar] [CrossRef]
- El Ghaouth, A.; Wilson, C.; Wisniewski, M. Biologically-Based Alternatives to Synthetic Fungicides for the Control of Postharvest diseases of Fruit and Vegetables. In Diseases of Fruits and Vegetables, 1st ed.; Naqvi, S.A.M.H., Ed.; Kluwer Academic Publishers: Dordrecht, The Netherlands, 2004; pp. 511–536. [Google Scholar]
- Vardi, Y.; Reuveni, M. Antifungal activity of a new broad spectrum bio-fungicide in the controlling of plant diseases. Phytopathology 2009, 99, S134. [Google Scholar]
- Reuveni, M.; Neifeld, D. Timorex Gold—A novel organic fungicide for the control of plant diseases and black Sigatoka in banana. Acta Hortic. 2011, 811, 129–132. [Google Scholar]
- Patkowska, E.; Błażewicz-Woźniak, M.; Konopiński, M.; Wach, D. Effect of cover crops on the fungal and bacterial communities in the soil under carrot cultivation. Plant Soil Environ. 2016, 62, 237–242. [Google Scholar] [CrossRef]
- Borowy, A. Growth and yield of ‘Hamburg’ parsley under no-tillage cultivation using white mustard as a cover crop. Acta Sci. Pol. Hortorum Cultus 2013, 12, 13–32. [Google Scholar]
- Kołota, E.; Adamczewska-Sowińska, K. Living mulches in vegetable crops production: Perspectives and limitations (a review). Acta Sci. Pol. Hortorum Cultus 2013, 12, 127–142. [Google Scholar]
- Sánchez-Montesinos, B.; Diánez, F.; Moreno-Gavíra, A.; Gea, F.J.; Santos, M. Role of Trichoderma aggressivum f. europaeum as Plant-Growth Promoter in Horticulture. Agronomy 2020, 10, 1004. [Google Scholar] [CrossRef]
- ALKahtani, M.D.F.; Attia, K.A.; Hafez, Y.M.; Khan, N.; Eid, A.M.; Ali, M.A.M.; Abdelaal, K.A.A. Chlorophyll Fluorescence Parameters and Antioxidant Defense System Can Display Salt Tolerance of Salt Acclimated Sweet Pepper Plants Treated with Chitosan and Plant Growth Promoting Rhizobacteria. Agronomy 2020, 10, 1180. [Google Scholar] [CrossRef]
- Al-Tawaha, A.M.; Seguin, P.; Smith, D.L.; Beaulieu, C. Foliar application of elicitors alters isoflavone concentrations and other seed characteristics of field-grown soybean. Can. J. Plant Sci. 2006, 86, 677–684. [Google Scholar] [CrossRef]
- Khan, N.; Bano, A.M.; Babar, A. Impacts of plant growth promoters and plant growth regulators on rainfed agriculture. PLoS ONE 2020, 15, e0231426. [Google Scholar] [CrossRef] [PubMed]
- Vejan, P.; Abdullah, R.; Khadiran, T.; Ismail, S.; Nasrulhaq Boyce, A. Role of Plant Growth Promoting Rhizobacteria in Agricultural Sustainability-A Review. Molecules 2016, 21, 573. [Google Scholar] [CrossRef] [PubMed]
- Khan, M.R.; Mohiddin, F.A. Trichoderma: Its Multifarious Utility in Crop Improvement. In New and Future Developments in Microbial Biotechnology and Bioengineering. Crop Improvement through Microbial Biotechnology, 1st ed.; Khan, M.R.; Mohiddin, F.A. Elsevier, B.V.: Amsterdam, The Netherlands, 2018; pp. 263–291. [Google Scholar] [CrossRef]
- Druzhinina, I.S.; Seidl-Seiboth, V.; Herrera-Estrella, A.; Horwitz, B.A.; Kenerley, C.M.; Monte, E.; Mukherjee, P.K.; Zeilinger, S.; Grigoriev, I.V.; Kubicek, C.P. Trichoderma: The genomics of opportunistic success. Nat. Rev. Microbiol. 2011, 16, 749–759. [Google Scholar] [CrossRef] [PubMed]
- Strakowska, J.; Błaszczyk, L.; Chełkowski, J. The significance of cellulolytic enzymes produced by Trichoderma in opportunistic lifestyle of this fungus. J. Basic Microbiol. 2014, 54, 1–12. [Google Scholar] [CrossRef]
- Woo, S.L.; Ruocco, M.; Vinale, F.; Nigro, M.; Marra, R.; Lombardi, N.; Pascale, A.; Lanzuise, S.; Manganiello, G.; Lorito, M. Trichoderma-based products and their widespread use in agriculture. Open Mycol. J. 2014, 8, 71–126. [Google Scholar] [CrossRef]
- Wojtkowiak-Gębarowska, E. Mechanizmy zwalczania fitopatogenów glebowych przez grzyby z rodzaju Trichoderma. Post. Mikrobiol. 2006, 45, 261–273. [Google Scholar]
- Harman, G.; Howell, C.; Viterbo, A.; Chet, I.; Lorito, M. Trichoderma species—opportunistic, avirulent plant symbionts. Nat. Rev. Microbiol. 2004, 2, 43–56. [Google Scholar] [CrossRef]
- Selitrennikoff, C.P. Antifungal proteins. Appl. Environ. Microbiol. 2001, 67, 2883–2894. [Google Scholar] [CrossRef]
- Abbas, A.; Jiang, D.; Fu, Y. Trichoderma spp. as antagonist of Rhizoctonia solani. J. Plant Pathol. Microbiol. 2017, 8, 402. [Google Scholar] [CrossRef]
- Błaszczyk, L.; Siwulski, M.; Sobieralski, K.; Lisiecka, J.; Jędryczka. Trichoderma spp.—Application and prospects for use in organic farming and industry. J. Plant Prot. Res. 2014, 54, 309–317. [Google Scholar] [CrossRef]
- Leelavathi, M.S.; Vani, L.; Reena, P. Antimicrobial activity of Trichoderma harzianum against bacteria and fungi. Internat. J. Curr. Microbiol. Appl. Sci. 2014, 3, 96–103. [Google Scholar]
- Vinale, F.; Sivasithamparam, K.; Ghisalberti, E.L.; Marra, R.; Woo, S.L.; Lorito, M. Trichoderma – plant-pathogen interactions. Soil Biol. Biochem. 2008, 40, 1–10. [Google Scholar] [CrossRef]
- Ferrigo, D.; Raiola, A.; Picollo, E.; Scopel, C.; Causin, R. Trichoderma harzianum T22 induces in maize systemic resistance against Fusarium verticillioides. J. Plant. Pathol. 2014, 96, 133–142. [Google Scholar] [CrossRef]
- Wang, G.; Cao, X.; Ma, X.; Guo, M.; Liu, C.; Yan, L.; Bian, Y. Diversity and effect of Trichoderma spp. associated with green mold disease on Lentinula edodes in China. MicrobiologyOpen 2016, 5, 709–718. [Google Scholar] [CrossRef]
- Kumar, S.; Thakur, M.; Rani, A. Trichoderma: Mass production, formulation, quality control, delivery and its scope in commercialization in India for the management of plant diseases. Afr. J. Agric. Res. 2014, 9, 3838–3852. [Google Scholar] [CrossRef]
- López-Bucio, J.; Pelagio-Flores, R.; Herrera-Estrella, A. Trichoderma as biostimulant: Exploiting the multilevel properties of a plant beneficial fungus. Sci. Hortic. 2015, 196, 109–123. [Google Scholar] [CrossRef]
- Katiyar, D.; Hemantaranjan, A.; Singh, B. Chitosan as a promising natural compound to enhance potential physiological responses in plant: A review. Indian J. Plant Physiol. 2015, 20, 1–9. [Google Scholar] [CrossRef]
- Younes, I.; Rinaudo, M. Chitin and Chitosan Preparation from Marine Sources. Structure, Properties and Applications. Mar. Drugs. 2015, 13, 1133–1174. [Google Scholar] [CrossRef]
- Kaczmarek, M.B.; Struszczyk-Swita, K.; Li, X.; Szczęsna-Antczak, M.; Daroch, M. Enzymatic Modifications of Chitin, Chitosan, and Chitooligosaccharides. Front. Bioeng. Biotechnol. 2019, 7, 243. [Google Scholar] [CrossRef] [PubMed]
- Xing, K.; Zhu, X.; Peng, X.; Qin, S. Chitosan antimicrobial and eliciting properties for pest control in agriculture: A review. Agron. Sustain. Dev. 2015, 35, 569–588. [Google Scholar] [CrossRef]
- El Hadrami, A.; Adam, A.R.; El Hadrami, I.; Daayf, F. Chitosan in plant protection. Mar. Drugs. 2010, 8, 968–987. [Google Scholar] [CrossRef]
- Carson, C.F.; Hammer, K.A.; Riley, T.V. Melaleuca alternifolia (Tea Tree) Oil: A Review of Antimicrobial and Other Medicinal Properties. Clin. Microbiol. Rev. 2006, 19, 50–62. [Google Scholar] [CrossRef] [PubMed]
- Rudbäck, J.; Bergström, M.A.; Börje, A.; Nilsson, U.; Karlberg, A.-T. α-terpinene, an antioxidant in tea tree oil, autoxidizes rapidly to skin allergens on air exposure. Chem. Res. Toxicol. 2012, 25, 713–721. [Google Scholar] [CrossRef]
- Jamiołkowska, A.; Hetman, B. Mechanizm działania preparatów biologicznych stosowanych w ochronie roślin przed patogenami. Ann. UMCS Sectio E Agric. 2016, LXXI, 13–29. [Google Scholar]
- Angelini, P.; Pagiotti, R.; Menghini, A.; Vianello, B. Antimicrobial activities of various essential oils against foodborne pathogenic or spoilage moulds. Ann. Microbiol. 2006, 56, 65–69. [Google Scholar] [CrossRef]
- Terzi, V.; Morcia, C.; Faccioli, P.; Valé, G.; Tacconi, G.; Malnati, M. In vitro antifungal activity of the tea tree (Melaleuca alternifolia). Essentials oil and its major components against plant pathogens. Lett. Appl. Microbiol. 2007, 44, 613–618. [Google Scholar] [CrossRef]
- Le, T.K.; Nguyen, T.T.H.; Le, T.T.T. Antifungal activity of tea tree essential oils (Melaleuca alternifolia) against phytopathogenic fungi. Int. J. Adv. Res. 2019, 7, 1239–1248. [Google Scholar] [CrossRef]
- Patkowska, E.; Konopiński, M. Pathogenicity of selected soil-borne microorganisms for scorzonera seedlings (Scorzonera hispanica L.). Folia Hort. 2008, 20/1, 31–42. [Google Scholar] [CrossRef][Green Version]
- Mielniczuk, E.; Patkowska, E.; Jamiołkowska, A. The influence of catch crops on fungal diversity in the soil and health of oat. Plant Soil Environ. 2020, 66, 99–104. [Google Scholar] [CrossRef]
- Patkowska, E.; Konopiński, M. Harmfulness of soil-borne fungi towards root chicory (Cichorium intybus L. var sativum Bisch.) cultivated with the use of cover crops. Acta Sci. Pol. Hortorum Cultus 2013, 12, 3–18. [Google Scholar]
- Patkowska, E.; Konopiński, M. Fungi threatening scorzonera (Scorzonera hispanica L.) cultivation using plant mulches. Acta Sci. Pol. Hortorum Cultus 2013, 12, 215–225. [Google Scholar]
- Pszczółkowska, A.; Okorski, A.; Fordoński, G.; Kotecki, A.; Kozak, M.; Dzienis, G. Effect of Weather Conditions on Yield and Health Status of Faba Bean Seeds in Poland. Agronomy 2020, 10, 48. [Google Scholar] [CrossRef]
- Barnett, H.L.; Hunter, B.B. Ilustrated Genera of Imperfect Fungi; Burgess Publishing Company: Minneapolis, MN, USA, 1972; p. 241. [Google Scholar]
- Booth, G. The genus Fusarium; Commonwealth Mycological Institute Kew: Surrey, UK, 1971; p. 237. [Google Scholar]
- De Vries, A.G. Contribution to the Knowledge of the Genus Cladosporium Link ex Fr.; Baarn Hitgeverij & Drukkeryij: Baarn, The Netherlands, 1952; p. 121. [Google Scholar]
- Domsch, K.H.; Gams, W. Pilze aus Agrarböden; G. Fischer Verlag: Stuttgart, Germany, 1970; p. 222. [Google Scholar]
- Domsch, K.W.; Gams, W.; Hudson, P.S. Fungi in Agricultural Soils; Longman: Edinbourgh, UK, 1970; p. 290. [Google Scholar]
- Domsch, K.H.; Gams, W.; Anderson, T.H. Compendium of Soil Fungi; Academic Press: London, UK, 1980; p. 860. [Google Scholar]
- Ellis, M.B. Dematiaceous Hyphomycetes; Commonwealth Mycological Institute Kew: Surrey, UK, 1971; p. 608. [Google Scholar]
- Ellis, M.B.; Ellis, J.P. Microfungi on Land Plants. An Identification Handbook; Macmillan Publishing Co.: New York, NY, USA, 1985; p. 868. [Google Scholar]
- Gillman, J.C. A Manual of Soil Fungi; The Iowa State Coll. Press: Iowa, IA, USA, 1957; p. 450. [Google Scholar]
- Kwaśna, H.; Chełkowski, J.; Zajkowski, P. Grzyby (Mycota), tom 22. Sierpik (Fusarium); Institute of Botany of the Polish Academy of Sciences: Warsaw–Krakow, Poland, 1991; p. 137. [Google Scholar]
- Marcinkowska, J. Oznaczanie Rodzajów Grzybów Ważnych w Patologii Roślin; Foundation “Development of SGGW”: Warsaw, Poland, 2003; p. 328. [Google Scholar]
- Marcinkowska, J. Oznaczanie Rodzajów Ważnych Organizmów Fitopatologicznych (Fungi, Oomycota, Plasmodiophorida); SGGW Press: Warsaw, Poland, 2010; p. 216. [Google Scholar]
- Nelson, P.E.; Toussoun, Y.A.; Marasas, W.F.O. Fusarium species. In An Illustrated Manunal for Identification; Pensylvania State University Press: Pensylvania, PA, USA, 1983; p. 193. [Google Scholar]
- Raper, K.B.; Thom, C.; Fennel, D.J. A Manual of the Penicillium; Hafner Publishing Company: New York, NY, USA, 1968; p. 875. [Google Scholar]
- Rifai, M.A. A Revision of the Genus Trichoderma; Commonwealth Mycological Institute: Surrey, UK, 1969; p. 56. [Google Scholar]
- Watanabe, T. Pictorial Atlas of Soil and Seed Fungi; CRC Press: Boca Raton, FL, USA, 2002; p. 504. [Google Scholar]
- Leslie, J.F.; Summerell, B.A. The Fusarium Laboratory Manual; Blackwell Publishing Professional: Ames, IA, USA, 2006; p. 388. [Google Scholar]
- Ramirez, C. Manual and Atlas of the Penicillia; Elsevier Biomedical Press Amsterdam: New York, NY, USA, 1982; p. 874. [Google Scholar]
- Czaban, J.; Gajda, A.; Wróblewska, B. The mobility of bacteria from rhizosphere and different zones of winter wheat roots. Pol. J. Environ. Stud. 2007, 16, 301–308. [Google Scholar]
- Patkowska, E.; Jamiołkowska, A.; Mielniczuk, E. Antagonistic fungi in the soil after Daucus carota L. cultivation. Plant Soil Environ. 2019, 65, 159–164. [Google Scholar] [CrossRef]
- Mańka, K.; Kowalski, S. A new method for evaluating interaction between soil inhibiting fungi and plant pathogen. Bulletin OILB/SROP 1992, 15, 73–77. [Google Scholar]
- Mańka, K.; Kowalski, S. The effect of communities of soil-borne fungi from two forest nurseries (pine and ash) on the development of necrotic fungus Fusarium oxysporum Schl.). Poznań Soc. Friends Sci. 1968, 25, 197–205. [Google Scholar]
- Pastucha, A. Chitosan as a compound inhibiting the occurrence of soybean diseases. Acta Sci. Pol. Hortorum Cultus 2008, 7, 41–55. [Google Scholar]
- Pięta, D.; Patkowska, E.; Pastucha, A. The protective effect of biopreparations applied as the dressing for common bean (Phaseolus vulgaris L.) and pea (Pisum sativum L.). Acta Sci. Pol. Hortorum Cultus 2005, 4, 59–67. [Google Scholar]
- Mangwende, E.; Kritzinger, Q.; Truter, M.; Aveling, T.A.S. Alternaria alternata: A new seed-transmitted disease of coriander in South Africa. Eur. J. Plant Pathol. 2018, 152, 409–416. [Google Scholar] [CrossRef]
- Ding, S.; Meinholz, K.; Cleveland, K.; Jordan, S.A.; Gevens, A.J. Diversity and virulence of Alternaria spp. causing potato early blight and brown spot in Wisconsin. Phytopathology 2019, 109, 436–445. [Google Scholar] [CrossRef]
- Kurzawińska, H.; Mazur, S.; Nawrocki, J. Microorganisms colonizing the leaves, shoots and roots of boxwood (Buxus sempervirens L.). Acta Sci. Pol. Hortorum Cultus 2019, 18, 151–156. [Google Scholar] [CrossRef]
- Tülek, S.; Dolar, F.S. Detection and identification of Alternaria species causing diseases of carrot in Ankara province, Turkey. Sci. Papers. Ser. B Hortic. 2015, LIX, 263–268. [Google Scholar]
- Farrar, J.J.; Pryor, B.M.; Davis, R.M. Alternaria diseases of carrot. Plant Dis. 2004, 88, 776–784. [Google Scholar] [CrossRef]
- Ahmad, L.; Siddiqui, Z.A. Effects of Meloidogyne incognita, Alternaria dauci and Fusarium solani on carrot in different types of soil. Acta Phytopat. Entomol. Hung. 2017, 52, 39–48. [Google Scholar] [CrossRef]
- Kathe, L.; Krämer, R.; Budahn, H.; Pillen, K.; Rabenstein, F.; Nothnagel, T. Characterisation of Alternaria radicina isolates and assessment of resistance in carrot (Daucus carota L.). J. für Kulturpflanzen 2017, 69, 277–290. [Google Scholar] [CrossRef]
- Mazur, S.; Waksmundzka, A. Effect of some compounds on the decay of strawberry fruits caused by Botrytis cinerea Pers. Meded. Rijksuniv. Gent. Fak. Landbouwkd. Toegep. Biol. Wet. 2001, 66, 227–231. [Google Scholar] [PubMed]
- Szczeponek, A.; Mazur, S.; Nawrocki, J. The Usage of Chitosan in Protection of Some Peppermint and Lemon Balm Pathogens; Polish Chitin Society: Łódź, Poland, 2006; pp. 193–200. [Google Scholar]
- Patkowska, E. The Application of Chitosan, Pythium oligandrum and Grapefruit Extract in the Protection of Common Bean (Phaseolus vulgaris L.) from Soil-borne Phytopathogens; Polish Chitin Society: Łódź, Poland, 2008; pp. 133–140. [Google Scholar]
- Sheikha, S.A.A.K.; Al-Malki, F.M. Growth and chlorophyll responses of bean plants to the chitosan applications. Eur. J. Sci. Res. 2011, 50, 124–134. [Google Scholar]
- Nakkeeran, S.; Renukadevi, P.; Aiyanathan, K. Exploring the Potential of Trichoderma for the Management of Seed and Soil-Borne Diseases of Crops; Springer: Dordrecht, The Netherlands, 2016; pp. 77–130. [Google Scholar]
- Orlikowski, L.B.; Skrzypczak, C. Biocides in the control of soil-borne and leaf pathogens. Hortic. Veget. Grow. 2003, 22, 426–433. [Google Scholar]
- Kurzawińska, H.; Mazur, S. The Effect of Chitosan and Pythium oligandrum Used in Protection of Potato Tubers Against Late Blight and Soft Rot; Polish Chitin Society: Łódź, Poland, 2008; pp. 117–123. [Google Scholar]
- Kurzawińska, H.; Mazur, S. The evaluation of Pythium oligandrum and chitosan in control of Phytophthora infestans (Mont.) de Bary on potato plants. Folia Hortic. 2009, 21, 13–23. [Google Scholar] [CrossRef]
- Włodarek, A.; Robak, J. Możliwości stosowania środków pochodzenia naturalnego w ochronie sałaty w uprawie polowej i pod osłonami przed chorobami. Zesz. Nauk. Inst. Ogrod. 2013, 21, 43–47. [Google Scholar]
- Pastucha, A.; Patkowska, E. Wpływ płynów pohodowlanych grzybów antagonistycznych na zdrowotność i plonowanie soi. Acta Agrobot. 2005, 58, 111–124. [Google Scholar] [CrossRef][Green Version]
- Haikal, N.Z. Control of Rhizoctonia solani in soybean (Glycine max L.) by seed-coating with Trichoderma viride and Gliocladium virens spores. J. Appl. Biosci. 2008, 1, 34–39. [Google Scholar]
- Rollán, M.C.; Mónaco, C.; Lampugnani, G.; Arteta, N.; Bayo, D.; Urrutia, M.I. Effects of post-emergent herbicides on Trichoderma harzianum, a potential biocontrol agent against Sclerotinia sclerotiorum in soybean cropping. Acta Agron. Hungar. 2007, 55, 355–362. [Google Scholar] [CrossRef]
- Nygren, K.; Dubey, M.; Zapparata, A.; Iqubal, M.; Tzelepis, G.D.; Durling, M.B.; Jensen, D.F.; Karlsson, M. The mycoparasitic fungus Clonostachys rosea responds with both common and specific gene expression during interspecific interactions with fungal prey. Evol. Appl. 2018, 11, 931–949. [Google Scholar] [CrossRef]
- Singh, U.B.; Malviya, D.; Singh, S.; Kumar, M.; Sahu, P.K.; Singh, H.V.; Kumar, S.; Roy, M.; Imran, M.; Rai, J.P.; et al. Trichoderma harzianum and methyl jasmonate-induced resistance to Bipolaris sorokiniana through enhanced phenylpropanoid activities in bread wheat (Triticum aestivum L.). Front. Microbiol. 2019, 10, 1697. [Google Scholar] [CrossRef]
- Li, X.; Zhang, T.; Wang, X.; Hua, K.; Zhao, L.; Han, Z. The composition of root exudates from two different resistant peanut cultivars and their effects on the growth of soil-borne pathogens. Int. J. Biol. Sci. 2013, 9, 164–173. [Google Scholar] [CrossRef]
- Patkowska, E. Effect of chitosan and Zaprawa Oxafun T on the healthiness and communities of rhizosphere microorganisms of runner bean (Phaseolus coccineus L.). Ecolog. Chem. Engin. S 2009, 16, 163–174. [Google Scholar]
- Patkowska, E. The effect of biopreparations on the formation of rhizosphere microorganism populations of soybean (Glycine max (L.) Merrill). Acta Sci. Pol. Hortorum Cultus 2005, 4, 89–99. [Google Scholar]
- Pięta, D.; Pastucha, A.; Patkowska, E. A Possibility of Using Grapefruit Extract, Chitosan and Pythium oligandrum to Protect Soybean (Glycine Max (L.) Merrill) from Pathogens; Polish Chitin Society: Łódź, Poland, 2007; pp. 197–203. [Google Scholar]
- Lucas, G.C.; Alves, E.; Pereira, R.B.; Perina, F.J.; Magela de Souza, R. Antibacterial activity of essential oils on Xanthomonas vesicatoria and control of bacteria spot in tomato. Pesq. Agropec. Bras. 2012, 47, 3. [Google Scholar] [CrossRef]
- Yu, D.; Wang, J.; Shao, X.; Xu, F.; Wang, H. Antifungal modes of action of tea tree oil and its two characteristic components against Botrytis cinerea. J. Appl. Microbiol. 2015, 119, 1253–1262. [Google Scholar] [CrossRef]
- Reuveni, M.; Pipko, G.; Neufeld, D.; Finkelstein, E.; Malka, B.; Hornik, Y. New organic formulations of essential tea tree oil for the control of plant diseases. Veget. Crop News 2006, 42, 77–85. [Google Scholar]
- Riccioni, L.; Orzali, L. Activity of tea tree (Malaleuca alternifolia, Chell) and thyme (Thymus vulgaris L.) essential oils against some pathogenic seed borne fungi. J. Essent. Oil Res. 2012, 23, 43–47. [Google Scholar] [CrossRef]
- Sood, M.; Kapoor, D.; Kumar, V.; Sheteiwy, M.S.; Ramakrishnan, M.; Landi, M.; Araniti, F.; Sharma, A. Trichoderma: The “Secrets” of a Multitalented Biocontrol Agent. Plants 2020, 9, 762. [Google Scholar] [CrossRef] [PubMed]
- Kumar, S. Trichoderma: A biological weapon for managing plant diseases and promoting sustainability. Int. J. Agric. Sci. Med. Vet. 2013, 1, 106–121. [Google Scholar]
- Fesel, P.H.; Zuccaro, A. β-glucan: Crucial component of the fungal cell wall and elusive MAMP in plants. Fungal Genet. Biol. 2016, 90, 53–60. [Google Scholar] [CrossRef]
- Hu, M.; Li, Q.-L.; Yang, Y.-B.; Liu, K.; Miao, C.-P.; Zhao, L.-X.; Ding, Z.-T. Koninginins RS from the endophytic fungus Trichoderma koningiopsis. Nat. Prod. Res. 2017, 31, 835–839. [Google Scholar] [CrossRef] [PubMed]
- Turaga, V.N.R. Peptaibols: Antimicrobial Peptides from Fungi. In Bioactive Natural Products in Drug Discovery; Singh, J., Meshram, V., Gupta, M., Eds.; Springer: Berlin/Heidelberg, Germany, 2020; pp. 713–730. [Google Scholar]
- Manganiello, G.; Sacco, A.; Ercolano, M.R.; Vinale, F.; Lanzuise, S.; Pascale, A.; Napolitano, M.; Lombardi, N.; Lorito, M.; Woo, S.L. Modulation of tomato response to Rhizoctonia solani by Trichoderma harzianum and it secondary metabolite harzianic acid. Front. Microbiol. 2018, 9, 1966. [Google Scholar] [CrossRef]
- Brito, J.P.C.; Ramada, M.H.S.; de Magalhães, M.T.Q.; Silva, L.P.; Ulhoa, C.J. Peptaibols from Trichoderma asperellum TR356 strain isolated from Brazilian soil. SpringerPlus 2014, 3, 1–10. [Google Scholar] [CrossRef]
- Masi, M.; Nocera, P.; Reveglia, P.; Cimmino, A.; Evidente, A. Fungal Metabolites Antagonists towards Plant Pests and Human Pathogens: Structure-Activity Relationship Studies. Molecules 2018, 23, 834. [Google Scholar] [CrossRef] [PubMed]
- Alabouvette, C.; Olivain, C.; Migheli, Q.; Steinberg, C. Microbiological control of soil-borne phytopathogenic fungi with special emphasis on wilt-inducing Fusarium oxysporum. New Phytol. 2009, 184, 529–544. [Google Scholar] [CrossRef] [PubMed]
- Sarrocco, S.; Guidi, L.; Fambrini, S.; Degl’Innocenti, E.; Vannacci, G. Competition for cellulose exploitation between Rhizoctonia solani and two Trichoderma isolates in the decomposition of wheat straw. J. Plant Pathol. 2009, 91, 331–338. [Google Scholar]
- Srivastava, M.P.; Gupta, S.; Sharm, Y.K. Detection of siderophore production from different cultural variablesby CAS-agar plate assay. Asian J. Pharm. Pharmacol. 2018, 4, 66–69. [Google Scholar] [CrossRef]
- de La Cruz, J.; Hidalgo-Gallego, A.; Lora, J.M.; Benitez, T.; Pintor-Toro, J.A.; Llobell, A. Isolation and characterization of three chitinases from Trichoderma harzianum. Eur. J. Biochem. 1992, 206, 859–867. [Google Scholar] [CrossRef]
- Sivan, A.; Chet, I. Degradation of fungal cell walls by lytic enzymes of Trichoderma harzianum. Microbiology 1989, 135, 675–682. [Google Scholar] [CrossRef]
- Chet, I.; Harman, G.E.; Baker, R. Trichoderma hamatum: Its hyphal interactions with Rhizoctonia solani and Pythium spp. Microb. Ecol. 1981, 7, 29–38. [Google Scholar] [CrossRef]
- Patkowska, E.; Konopiński, M. Antagonistic activity of selected bacteria and fungi inhabiting the soil environment of salsify (Tragopogon porrifolius va. sativus (Gaterau) Br.) cultivated after cover crops. Acta Sci. Pol. Hortorum Cultus 2014, 13, 33–48. [Google Scholar]
- Patkowska, E.; Błażewicz-Woźniak, M.; Konopiński, M. Antagonistic activity of selected fungi occurring in the soil after root chicory cultivation. Plant Soil Environ. 2015, 61, 55–59. [Google Scholar] [CrossRef]
- Herrera-Téllez, V.I.; Cruz-Olmedo, A.K.; Plasencia, J.; Gavilanes-Ruíz, M.; Arce-Cervantes, O.; Hernández-León, S.; Saucedo-García, M. The Protective Effect of Trichoderma asperellum on Tomato Plants against Fusarium oxysporum and Botrytis cinerea Diseases Involves Inhibition of Reactive Oxygen Species Production. Int. J. Mol. Sci. 2019, 20, 2007. [Google Scholar] [CrossRef]
- Iqbal, M.N.; Ashraf, A. Trichoderma: A Potential Biocontrol Agent for Soilborne Fungal Pathogens. Int. J. Mol. Microbiol. 2019, 2, 22–24. Available online: https://journals.psmpublishers.org/index.php/ijmm (accessed on 12 September 2020).
- Błaszczyk, L.; Basińska, A.; Ćwiek, H.; Gromadzka, K.; Popiel, D.; Stępień, Ł. Suppressive effect of Trichoderma on toxigenic Fusarium species. Pol. J. Microbiol. 2017, 1, 85–100. [Google Scholar] [CrossRef] [PubMed]
- Popiel, D.; Kwaśna, H.; Chełkowski, J.; Stępień, Ł.; Laskowska, M. Impact of selected antagonistic fungi on Fusarium species—Toxigenic cereal pathogens. Acta Mycol. 2008, 43, 29–40. [Google Scholar] [CrossRef]
- Gveroska, B.; Ziberoski, J. Trichoderma harzianum as a biocontrol agent against Alternaria alternata on tobacco. Appl. Tech. Innov. 2012, 7, 67–76. [Google Scholar] [CrossRef]
- Zeng, W.; Kirk, W.; Hao, J. Field management of Sclerotinia stem rot of soybean using biological control agents. Biol. Control 2012, 60, 141–147. [Google Scholar] [CrossRef]
- Smolińska, U.; Kowalska, B. Biological control of the soil-borne fungal pathogen Sclerotinia sclerotiorum––a review. J. Plant Pathol. 2018, 100, 1–12. [Google Scholar] [CrossRef]
- Roberti, R.; Bergonzoni, F.; Finestrelli, A.; Leonardi, P. Biocontrol of Rhizoctonia solani disease and biostimulant effect by microbial products on bean plants. Micol. Italiana 2015, 44, 49–61. [Google Scholar] [CrossRef]

| Experimental Treatment | Field Stand per 1 m2 | Diseased Seedlings (%) | ||||||
|---|---|---|---|---|---|---|---|---|
| 2014 | 2015 | 2016 | Mean | 2014 | 2015 | 2016 | Mean | |
| Trianum P | 84.8 a | 91.4 a | 76.2 a | 84.1 a | 1.5 c | 2.5 c | 3.0 c | 2.3 c |
| Beta-Chikol | 76.6 b | 83.6 b | 63.6 | 74.6 b | 2.5 c | 4.0 bc | 4.5 c | 3.6 c |
| Timorex Gold 24 EC | 75.0 b | 81.4 b | 61.0 b | 72.4 b | 5.0 b | 7.5 b | 8.5 b | 7.0 b |
| Zaprawa Nasienna T 75 DS/WS | 82.4 a | 90.6 a | 73.4 a | 82.1 a | 2.0 c | 3.0 c | 4.0 c | 3.0 c |
| Control | 62.2 c | 70.0 c | 52.2 c | 61.4 c | 9.5 a | 11.5 a | 13.0 a | 11.3 a |
| Microorganisms | Experimental Treatment/Number of Isolates | |||||
|---|---|---|---|---|---|---|
| A | B | C | D | E | Total | |
| Alternaria alternata (Fr.) Keissler | 5 | 9 | 11 | 7 | 15 | 47 |
| Alternaria consortialis (Thüm.) J.W. Groves and S. Hughes | 1 | 5 | 7 | 3 | 8 | 24 |
| Alternaria dauci (Kühn) Groves and Skolko | 11 | 20 | 26 | 15 | 34 | 106 |
| Alternaria radicina Meier, Drechsler and Eddy | 12 | 24 | 31 | 17 | 39 | 123 |
| Clonostachys rosea (Link) Schroers, Samuels, Seifert | 7 | 5 | 4 | - | - | 16 |
| Cylindrocarpon didymum (Harting) Wollenw. | 2 | 7 | 9 | 4 | 11 | 33 |
| Epicoccum nigrum Link | 6 | 15 | 19 | 10 | 25 | 75 |
| Fusarium culmorum (W.G.Sm.) Sacc. | 17 | 29 | 34 | 22 | 43 | 145 |
| Fusarium oxysporum Schl. | 34 | 54 | 63 | 42 | 85 | 278 |
| Globisporangium irregulare (Buisman) Uzuhashi, Tojo and Kakish. | 4 | 8 | 10 | 6 | 15 | 43 |
| Neocosmospora solani (Mart.) L. Lombard and Crous | 5 | 10 | 12 | 7 | 13 | 47 |
| Penicillium lividum Westling | 8 | 16 | 20 | 12 | 24 | 80 |
| Penicillium thomii Marie | - | 5 | 8 | 3 | 10 | 26 |
| Phytophthora sp. | 9 | 22 | 27 | 14 | 33 | 105 |
| Rhizoctonia solani J.G. Kühn | 22 | 38 | 46 | 30 | 58 | 194 |
| Trichoderma sp. | 17 | 11 | 6 | 3 | - | 37 |
| Total isolates | 160 | 278 | 333 | 195 | 413 | 1379 |
| Microorganisms | Experimental Treatment/Number of Isolates | |||||
|---|---|---|---|---|---|---|
| A | B | C | D | E | Total | |
| Alternaria alternata (Fr.) Keissler | 2 | 5 | 6 | 3 | 8 | 24 |
| Alternaria chartarum Preuss | 2 | 4 | 6 | 3 | 8 | 23 |
| Alternaria consortialis (Thüm.) J.W. Groves and S. Hughes | 4 | 6 | 6 | 5 | 8 | 29 |
| Alternaria dauci (Kühn) Groves and Skolko | 8 | 15 | 18 | 12 | 24 | 77 |
| Alternaria radicina Meier, Drechsler and Eddy | 7 | 12 | 14 | 9 | 18 | 60 |
| Arthrinium phaeospermum (Corda) M.B. Ellis | - | - | 2 | - | 5 | 7 |
| Cylindrocarpon didymum (Harting) Wollenw. | - | 5 | 7 | - | 12 | 24 |
| Epicoccum nigrum Link | 1 | 6 | 10 | 1 | 15 | 33 |
| Fusarium avenaceum (Fr.) Sacc. | - | - | - | - | 3 | 3 |
| Fusarium culmorum (W.G.Sm.) Sacc. | 3 | 7 | 9 | 5 | 13 | 37 |
| Fusarium oxysporum Schl. | 25 | 37 | 44 | 31 | 56 | 193 |
| Gliomastix murorum (Corda) S. Hughes | - | - | 6 | - | 11 | 17 |
| Neocosmospora solani (Mart.) L. Lombard and Crous | 1 | 5 | 9 | 1 | 15 | 31 |
| Mucor plumbeus Bonord. | 3 | 7 | 9 | 5 | 11 | 35 |
| Penicillium dierckxii Biourge | 9 | 14 | 19 | 11 | 25 | 78 |
| Penicillium janczewskii Zalessky | 7 | 14 | 17 | 10 | 23 | 71 |
| Rhizopus stolonifer (Ehrenb.) Vuill. | - | 3 | 5 | - | 12 | 20 |
| Rhizoctonia solani J.G. Kühn | 4 | 8 | 9 | 6 | 15 | 42 |
| Sclerotinia sclerotiorum (Lib.) de Bary | 40 | 60 | 69 | 49 | 89 | 307 |
| Torula herbarum (Pers.) Link | - | - | 1 | - | 3 | 4 |
| Trichoderma sp. | 20 | 14 | 11 | 2 | - | 47 |
| Total isolates | 136 | 222 | 277 | 153 | 374 | 1162 |
| Experimental Treatment | Total CFU of Bacteria (106/g of Soil DW) | CFU of Bacillus sp. (106/g of Soil DW) | CFU of Pseudomonas sp. (106/g of Soil DW) | Total CFU of Fungi (103/g of Soil DW) | ||||||||||||
|---|---|---|---|---|---|---|---|---|---|---|---|---|---|---|---|---|
| 2014 | 2015 | 2016 | Mean | 2014 | 2015 | 2016 | Mean | 2014 | 2015 | 2016 | Mean | 2014 | 2015 | 2016 | Mean | |
| Trianum P | 5.08 a | 7.12 a | 8.26 a | 6.82 a | 3.10 a | 5.16 a | 5.83 a | 4.70 a | 1.80 a | 1.62 a | 2.24 a | 1.88 a | 2.56 c | 3.82 c | 3.52 c | 3.30 c |
| Beta-Chikol | 3.14 b | 4.25 b | 6.15 b | 4.51 b | 2.13 b | 3.20 b | 4.14 b | 3.16 b | 1.00 a,b | 1.02 a,b | 1.92 a | 1.31 a,b | 4.98 b | 5.98 b | 6.15 b | 5.70 b |
| Timorex Gold 24 EC | 3.10 b | 4.16 b | 5.84 b | 4.36 b | 2.12 b | 3.10 b | 4.02 b | 3.08 b | 0.75 b | 0.43 b | 0.54 b | 0.57 b | 5.14 b | 6.50 b | 6.84 b | 6.16 b |
| Zaprawa Nasienna T 75 DS/WS | 5.24 a | 7.34 a | 8.45 a | 7.01 a | 3.14 a | 5.28 a | 6.00 a | 4.81 a | 2.05 a | 2.00 a | 2.31 a | 2.12 a | 2.32 c | 3.68 c | 3.14 c | 3.05 c |
| Control | 1.08 c | 2.06 c | 3.00 c | 2.05 c | 0.52 c | 1.15 c | 1.32 c | 0.99 c | 0.12 c | 0.23 b | 0.34 b | 0.23 b | 9.64 a | 9.92 a | 8.56 a | 9.37 a |
| Fungus Species | Experimental Treatment/Number of Isolates | |||||
|---|---|---|---|---|---|---|
| A | B | C | D | E | Total | |
| Albifimbria verrucaria (Alb. and Schwein.) L. Lombard and Crous | 20 | 19 | 12 | - | - | 51 |
| Alternaria alternata (Fr.) Keissler | 7 | 14 | 16 | 10 | 23 | 70 |
| Alternaria chartarum Preuss | 1 | 3 | 5 | 2 | 6 | 17 |
| Alternaria dauci (Kühn) Groves and Skolko | - | 1 | 4 | - | 8 | 13 |
| Alternaria radicina Meier, Drechsler and Eddy | - | - | 2 | - | 4 | 6 |
| Aspergillus fumigatus Fresen. | 4 | 7 | 8 | 6 | 12 | 37 |
| Cladosporium herbarum (Pers.) Link | 3 | 8 | 12 | 6 | 17 | 46 |
| Clonostachys rosea (Link) Schroers, Samuels, Seifert | 20 | 18 | 8 | 2 | - | 48 |
| Epicoccum nigrum Link | 1 | 7 | 11 | 2 | 18 | 39 |
| Fusarium avenaceum (Fr.) Sacc. | 1 | 7 | 10 | 3 | 18 | 39 |
| Fusarium culmorum (W.G.Sm.) Sacc. | 8 | 12 | 14 | 10 | 20 | 64 |
| Fusarium oxysporum Schl. | 30 | 41 | 51 | 36 | 74 | 232 |
| Gliomastix murorum (Corda) S. Hughes | - | 3 | 5 | - | 9 | 17 |
| Mucor racemosus Fresenius | 6 | 12 | 16 | 8 | 24 | 66 |
| Neocosmospora solani (Mart.) L. Lombard and Crous | 1 | 3 | 5 | 1 | 8 | 18 |
| Penicillium aurantiogriseum Dierckx | 8 | 6 | 3 | 5 | 10 | 32 |
| Penicillium glabrum (Wehmer) Westling | 9 | 4 | 2 | 7 | 15 | 37 |
| Rhizoctonia solani J.G. Kühn | 18 | 29 | 36 | 22 | 49 | 154 |
| Rhizopus stolonifer (Ehrenb.) Vuill. | 7 | 16 | 21 | 11 | 33 | 88 |
| Sarocladium kiliense (Grütz) Summerb. | - | - | 2 | - | 5 | 7 |
| Sclerotinia sclerotiorum (Lib.) de Bary | 9 | 13 | 15 | 11 | 19 | 67 |
| Talaromyces flavus (Klöcker) Stolk and Samson | 14 | 10 | 3 | 6 | 20 | 53 |
| Talaromyces stipitatus (Thom ex C.W. Emmons) C.R. Benj. | 4 | 10 | 14 | 7 | 16 | 51 |
| Trichoderma sp. | 50 | 51 | 34 | 7 | - | 142 |
| Total isolates | 221 | 294 | 309 | 162 | 408 | 1394 |
| Fungi | Number of Isolates | Alternaria dauci | Alternaria radicina | Rhizoctonia solani | Sclerotinia sclerotiorum | ||||
|---|---|---|---|---|---|---|---|---|---|
| IBE* | GBE** | IBE* | GBE** | IBE* | GBE** | IBE* | GBE** | ||
| Trianum P | |||||||||
| Albifimbria verrucaria (Alb. and Schwein.) L. Lombard and Crous | 20 | +5 | +100 | +5 | +100 | +4 | +80 | +3 | +60 |
| Clonostachys rosea (Link) Schroers, Samuels, Seifert | 20 | +6 | +120 | +7 | +140 | +4 | +80 | +4 | +80 |
| Penicillium aurantiogriseum Dierckx | 8 | +2 | +16 | +2 | +16 | +1 | +8 | +2 | +16 |
| Penicillium glabrum (Wehmer) Westling | 9 | +1 | +9 | +1 | +9 | +1 | +9 | +1 | +9 |
| Talaromyces flavus (Klöcker) Stolk and Samson | 14 | +3 | +42 | +4 | +56 | +3 | +42 | +2 | +28 |
| Trichoderma sp. | 50 | +8 | +400 | +8 | +400 | +8 | +400 | +8 | +400 |
| Number of isolates | 121 | ||||||||
| SBE*** | +687 | +721 | +619 | +593 | |||||
| Beta-Chikol | |||||||||
| Albifimbria verrucaria (Alb. and Schwein.) L. Lombard and Crous | 19 | +5 | +95 | +5 | +95 | +4 | +76 | +3 | +57 |
| Clonostachys rosea (Link) Schroers, Samuels, Seifert | 18 | +6 | +108 | +7 | +126 | +4 | +72 | +4 | +74 |
| Penicillium aurantiogriseum Dierckx | 6 | +2 | +12 | +2 | +12 | +1 | +6 | +2 | +12 |
| Penicillium glabrum (Wehmer) Westling | 4 | +1 | +4 | +1 | +4 | +1 | +4 | +1 | +4 |
| Talaromyces flavus (Klöcker) Stolk and Samson | 10 | +3 | +30 | +4 | +40 | +3 | +30 | +2 | +20 |
| Trichoderma sp. | 51 | +8 | +408 | +8 | +408 | +8 | +408 | +8 | +408 |
| Number of isolates | 108 | ||||||||
| SBE*** | +657 | +685 | +596 | +575 | |||||
| Timorex Gold 24 EC | |||||||||
| Albifimbria verrucaria (Alb. and Schwein.) L. Lombard and Crous | 12 | +5 | +60 | +5 | +60 | +4 | +48 | +3 | +36 |
| Clonostachys rosea (Link) Schroers, Samuels, Seifert | 8 | +6 | +48 | +7 | +56 | +4 | +32 | +4 | +32 |
| Penicillium aurantiogriseum Dierckx | 3 | +2 | +6 | +2 | +6 | +1 | +3 | +2 | +6 |
| Penicillium glabrum (Wehmer) Westling | 2 | +1 | +2 | +1 | +2 | +1 | +2 | +1 | +2 |
| Talaromyces flavus (Klöcker) Stolk and Samson | 3 | +3 | +9 | +4 | +12 | +3 | +9 | +2 | +6 |
| Trichoderma sp. | 34 | +8 | +272 | +8 | +272 | +8 | +272 | +8 | +272 |
| Number of isolates | 62 | ||||||||
| SBE*** | +397 | +408 | +366 | +354 | |||||
| Zaprawa Nasienna T 75 DS/WS | |||||||||
| Clonostachys rosea (Link) Schroers, Samuels, Seifert | 2 | +6 | +12 | +7 | +14 | +4 | +8 | +4 | +8 |
| Penicillium aurantiogriseum Dierckx | 5 | +2 | +10 | +2 | +10 | +1 | +5 | +2 | +10 |
| Penicillium glabrum (Wehmer) Westling | 7 | +1 | +7 | +1 | +7 | +1 | +7 | +1 | +7 |
| Talaromyces flavus (Klöcker) Stolk and Samson | 6 | +3 | +18 | +4 | +24 | +3 | +18 | +2 | +12 |
| Trichoderma sp. | 7 | +8 | +56 | +8 | +56 | +8 | +56 | +8 | +56 |
| Number of isolates | 27 | ||||||||
| SBE*** | +103 | +111 | +94 | +93 | |||||
| Control | |||||||||
| Penicillium aurantiogriseum Dierckx | 10 | +2 | +20 | +2 | +20 | +1 | +10 | +2 | +20 |
| Penicillium glabrum (Wehmer) Westling | 15 | +1 | +15 | +1 | +15 | +1 | +15 | +1 | +15 |
| Talaromyces flavus (Klöcker) Stolk and Samson | 18 | +3 | +54 | +4 | +72 | +3 | +54 | +2 | +36 |
| Number of isolates | 43 | ||||||||
| SBE*** | +89 | +107 | +79 | +71 | |||||
Publisher’s Note: MDPI stays neutral with regard to jurisdictional claims in published maps and institutional affiliations. |
© 2020 by the authors. Licensee MDPI, Basel, Switzerland. This article is an open access article distributed under the terms and conditions of the Creative Commons Attribution (CC BY) license (http://creativecommons.org/licenses/by/4.0/).
Share and Cite
Patkowska, E.; Mielniczuk, E.; Jamiołkowska, A.; Skwaryło-Bednarz, B.; Błażewicz-Woźniak, M. The Influence of Trichoderma harzianum Rifai T-22 and Other Biostimulants on Rhizosphere Beneficial Microorganisms of Carrot. Agronomy 2020, 10, 1637. https://doi.org/10.3390/agronomy10111637
Patkowska E, Mielniczuk E, Jamiołkowska A, Skwaryło-Bednarz B, Błażewicz-Woźniak M. The Influence of Trichoderma harzianum Rifai T-22 and Other Biostimulants on Rhizosphere Beneficial Microorganisms of Carrot. Agronomy. 2020; 10(11):1637. https://doi.org/10.3390/agronomy10111637
Chicago/Turabian StylePatkowska, Elżbieta, Elżbieta Mielniczuk, Agnieszka Jamiołkowska, Barbara Skwaryło-Bednarz, and Marzena Błażewicz-Woźniak. 2020. "The Influence of Trichoderma harzianum Rifai T-22 and Other Biostimulants on Rhizosphere Beneficial Microorganisms of Carrot" Agronomy 10, no. 11: 1637. https://doi.org/10.3390/agronomy10111637
APA StylePatkowska, E., Mielniczuk, E., Jamiołkowska, A., Skwaryło-Bednarz, B., & Błażewicz-Woźniak, M. (2020). The Influence of Trichoderma harzianum Rifai T-22 and Other Biostimulants on Rhizosphere Beneficial Microorganisms of Carrot. Agronomy, 10(11), 1637. https://doi.org/10.3390/agronomy10111637








